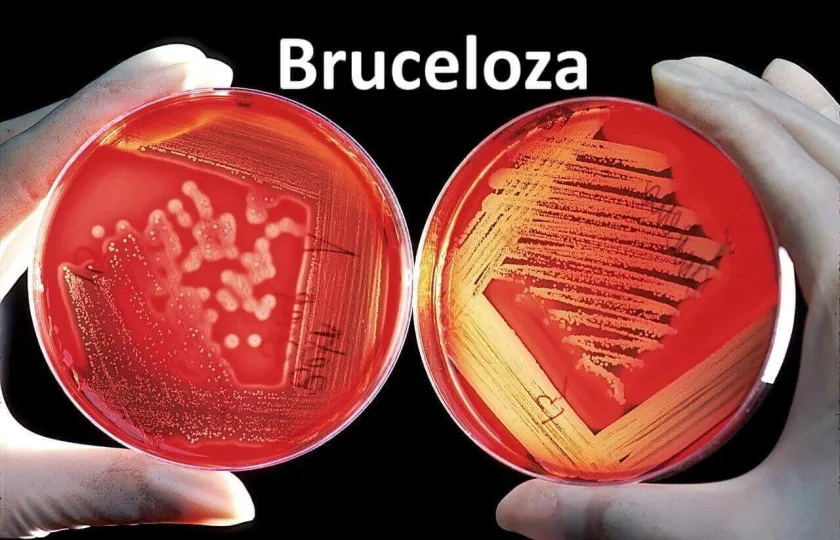
Bruceloza

Bruceloza jest chorobą zakaźną, która atakuje różne narządy i układy organizmu, a obraz kliniczny nie ma jasno określonej specyfiki. Bruceloza jest infekcją odzwierzęcą, jej czynnik sprawczy jest przenoszony na ludzi z chorych zwierząt. Bruceloza często staje się przewlekła, w ciężkich przypadkach może prowadzić do niepełnosprawności. Czynnikiem sprawczym brucelozy jest bakteria z rodzaju Brucella. Zidentyfikowano 8 odmian Brucella, z których 6 jest niebezpiecznych dla ludzi. Brucella – rodzaj Gram ujemnych bakterii będących przyczyną zakaźnej choroby – brucelozy. Brucella ma kształt małej pałeczki, nie posiada rzęsek (a więc zdolności ruchu), otoczki, nie wytwarza też przetrwalników. Brucella są przystosowane do warunków zewnętrznych: wytrzymują niskie temperatury, utrzymują się w glebie, na skórze i sierści zwierząt, w wodzie, mleku i mrożonym mięsie. W tych warunkach bakterie mogą żyć od 1,5 do 5 miesięcy. Gotowanie zabija mikroorganizmy natychmiast, po podgrzaniu do 60 ° C giną w ciągu 30 minut. Nasilenie choroby zależy od rodzaju Brucelli, przez którą jest spowodowana. Ostre i ciężkie przypadki choroby są częściej spowodowane przez Brucellamelitensis. Źródłem zakażenia brucelozą są zwierzęta. Infekcja jest przenoszona na ludzi głównie przez krowy, kozy, owce, świnie. Rzadziej - od wielbłądów, koni i innych zwierząt. Bakteria znajduje się w różnych płynach biologicznych zwierząt - mleku, kale, płynie owodniowym. Najczęściej do zakażenia dochodzi, gdy osoba spożywa zakażone mleko i produkty jego przetwarzania (kumys, ser feta, sery), przetwarza skórki, skóry chorych zwierząt.
Bruceloza u ludzi jest chorobą zakaźną, jej patogen może dostać się do organizmu na różne sposoby:
-
Spożywanie surowych produktów mlecznych, w tym lodów lub serów z niepasteryzowanego mleka i surowego mięsa;
-
Wdychanie pyłu zawierającego bakterie w gospodarstwach rolnych;
-
Bezpośredni kontakt z zakażonym zwierzęciem w przypadku zranienia (skaleczenia) na skórze człowieka;
-
Przeniesienie z matki na dziecko podczas porodu i karmienia piersią.
Bruceloza objawy
Okres inkubacji brucelozy u ludzi wynosi 1-2 tygodnie. Bruceloza rozwija się z reguły stopniowo i nie ma specyficznych objawów. Ale pacjenci zwykle zgłaszają cztery główne skargi:
-
Okresowe bóle stawów, głównie kończyn dolnych, czasami bardzo silne i bolesne.
-
Wzrost temperatury ciała w postaci przedłużonego stanu podgorączkowego (do 38 ° C) lub typu falowego z ostrymi wzrostami i spadkami.
-
Zwiększone pocenie się, pocenie się, czasami nocne poty.
-
Poważne osłabienie i utrata siły.
Zmiany ogólnoustrojowe są różnorodne i obejmują prawie wszystkie narządy. Spotykać się:
-
Układ mięśniowo-szkieletowy: septyczne zapalenie jednostawowe, asymetryczne zapalenie wielostawowe kolan, bioder, stawów krzyżowo-biodrowych i mostkowo-obojczykowych, zapalenie kości i szpiku kręgosłupa, bóle mięśni.
-
Serce: zapalenie wsierdzia, zapalenie mięśnia sercowego, zapalenie osierdzia, ropień korzenia aorty, zakrzepowe zapalenie żył i zapalenie wsierdzia mogą rozwinąć się na wcześniej niezmienionych zastawkach.
-
Układ oddechowy: zapalenie oskrzeli i zapalenie płuc.
-
Układ pokarmowy: zapalenie wątroby, jadłowstręt i utrata masy ciała.
-
Układ moczowo-płciowy: zapalenie najądrza, zapalenie jąder, zapalenie gruczołu krokowego, ropień jajowodu, zapalenie jajowodów, zapalenie szyjki macicy, ostre odmiedniczkowe zapalenie nerek.
-
Ośrodkowy układ nerwowy: zapalenie opon mózgowo-rdzeniowych, zapalenie opon mózgowo-rdzeniowych, zapalenie rdzenia kręgowego, ropnie mózgu, zespół Guillain-Barré, zanik nerwu wzrokowego, uszkodzenia par III, IV i VI.
-
Węzły chłonne, śledziona: zapalenie węzłów chłonnych, powiększona śledziona
-
Oczy: zapalenie rogówki, owrzodzenie rogówki, zapalenie błony naczyniowej oka, zapalenie wnętrza gałki ocznej.
Postacie kliniczne brucelozy:
-
Forma jest pierwotnie utajona;
-
Ostra postać septyczna;
-
Tworzą pierwotne przewlekłe przerzuty;
-
Tworzą wtórne przewlekłe przerzuty;
-
Wtórna postać utajona.
Pierwotny utajony stan zdrowia praktycznego. Wraz z osłabieniem sił ochronnych może przekształcić się w ostrą septyczną lub pierwotną przewlekłą postać przerzutową. Czasami mikroobjawy: niewielki wzrost obwodowych węzłów chłonnych, czasami wzrost temperatury ciała do stanów podgorączkowych, zwiększone pocenie się podczas wysiłku fizycznego. Uważają się za zdrowych i dalej pracują.
Ostra postać septyczna z gorączką (39-40°C), krzywa temperatury jest falista, nieregularna (septyczna) z dużymi zakresami dobowymi, powtarzającymi się dreszczami i potami. Stan zdrowia pozostaje dobry (przy temperaturze 39°C i wyższej może czytać książki, grać w szachy, oglądać telewizję). Nie ma innych objawów ogólnego zatrucia. Nie zagraża życiu pacjenta, nawet bez leczenia etiotropowego, kończy się wyzdrowieniem. Wszystkie grupy węzłów chłonnych są umiarkowanie powiększone, niektóre są wrażliwe. Pod koniec pierwszego tygodnia - wzrost wątroby i śledziony. W badaniu leukopenii krwi ESR nie wzrasta. Główną różnicą jest brak zmian ogniskowych (przerzutów). Bez antybiotykoterapii czas trwania gorączki wynosi 3-4 tygodnie lub dłużej.
Postacie przewlekłe czasami rozwijają się natychmiast, omijając postać ostrą, czasami po pewnym czasie po ostrej postaci septycznej. Według kliniki pierwotne przewlekłe przerzuty i wtórne przewlekłe przerzuty nie różnią się. Różnica polega na obecności lub braku ostrej postaci septycznej w historii. Objawy: przedłużona temperatura podgorączkowa, osłabienie, zwiększona drażliwość, zły sen, zaburzenia apetytu, zmniejszona wydajność. Uogólniona limfadenopatia jest miękka, wrażliwa lub bolesna przy badaniu palpacyjnym, występują małe, bardzo gęste, bezbolesne, sklerotyczne węzły chłonne (o średnicy 0,5-0,7 cm). Powiększenie wątroby i śledziony. Na tym tle wykrywane są zmiany narządowe, najczęściej ze strony układu mięśniowo-szkieletowego, w dalszej kolejności układu nerwowego i rozrodczego. Bóle mięśni i stawów, głównie dużych, zapalenie wielostawowe, z nowym zaostrzeniem pojawiają się przerzuty innej lokalizacji. Nie obserwuje się zapalenia okołostawowego, zapalenia okołostawowego, zapalenia kaletki, wyrośli, osteoporozy. Stawy puchną, ruchliwość w nich jest ograniczona, skóra nad nimi ma normalny kolor. Naruszenie ruchomości i deformacja są spowodowane wzrostem tkanki kostnej. Kręgosłup jest dotknięty, częściej w okolicy lędźwiowej. Ból mięśni w dotkniętych mięśniach. Bóle są tępe, długotrwałe, ich intensywność związana jest ze zmianami pogody. Podczas badania palpacyjnego określa się bardziej bolesne obszary, a w grubości mięśni odczuwa się bolesne pieczęcie o różnych kształtach i rozmiarach. Fibromialaga (gościec mięśniowo-ścięgnisty) w tkance podskórnej na nogach, przedramionach, plecach i dolnej części pleców. Rozmiary od 5-10 mm do 3-4 cm miękkie owalne formacje, bolesne lub wrażliwe. W przyszłości zmniejszają się, mogą całkowicie ustąpić lub stwardnieć i pozostać przez długi czas w postaci małych, gęstych formacji, bezbolesnych. Uszkodzenie układu nerwowego: zapalenie nerwu, zapalenie wielonerwowe, zapalenie korzonków nerwowych. Uszkodzenie ośrodkowego układu nerwowego (zapalenie rdzenia kręgowego, zapalenie opon mózgowo-rdzeniowych, zapalenie mózgu, zapalenie opon mózgowo-rdzeniowych) jest rzadkie, długotrwałe i trudne. Zmiany w układzie rozrodczym u mężczyzn – zapalenie jąder, zapalenie najądrzy, obniżenie funkcji seksualnych. U kobiet zapalenie jajowodów, zapalenie macicy, zapalenie błony śluzowej macicy. Występuje brak miesiączki, może rozwinąć się bezpłodność. Kobiety w ciąży często doświadczają poronień, martwych urodzeń, przedwczesnych porodów, wrodzonej brucelozy u dzieci. Wtórna postać przewlekła przebiega w ten sam sposób. Forma wtórnie utajona różni się od pierwotnej utajonej tym, że częściej przechodzi w formy jawne (nawroty).
Bruceloza objawy rozpoznanie
Aby wykryć brucelozę, oprócz zebrania wywiadu medycznego i zbadania pacjenta konieczna jest diagnostyka laboratoryjna. Przeprowadza się go w placówkach specjalnie wyposażonych do pracy z patogenami szczególnie groźnych infekcji. Aby wyizolować brucellę z krwi i innych płynów biologicznych, wysiewa się je na specjalnych pożywkach. Do postawienia diagnozy brucelozy wystarczy reakcja serologiczna oraz obecność antygenów brucelozy we krwi pacjenta.
Bruceloza objawy leczenie
Często brucelozę leczy się w szpitalu, ale w niektórych przypadkach leczenie ambulatoryjne jest dozwolone, jeśli pacjent ma łagodny przebieg choroby. Główną metodą leczenia jest wyznaczenie leków przeciwbakteryjnych, których działanie ma na celu zniszczenie patogennej mikroflory. W leczeniu brucelozy stosuje się antybiotyki, które mogą przenikać przez ścianę komórkową mikroorganizmu, osiągając w ten sposób efekt bakteriostatyczny. Oprócz tego zalecana jest terapia detoksykacyjna, która polega na dożylnym podawaniu roztworów infuzyjnych. Aby złagodzić gorączkę, stosuje się leki przeciwgorączkowe. Środki przeciwbólowe są przepisywane, jeśli pacjent odczuwa ból. Jeśli występują objawy uszkodzenia układu mięśniowo-szkieletowego, przepisywane są leki, zdolne do eliminacji procesu zapalnego, w szczególności niesteroidowe leki przeciwzapalne lub glikokortykosteroidy. Stosuje się również leki immunostymulujące, których działanie polega na pobudzeniu właściwości ochronnych organizmu.
Ponadto ćwiczenia fizjoterapeutyczne są zalecane w fazie remisji brucelozy. Program terapii ruchowej obejmuje szereg specjalnie zaprojektowanych ćwiczeń, a także wskazuje liczbę ćwiczeń i czas ich realizacji.
Bruceloza objawy rokowanie zapobieganie
Po całkowitym ustąpieniu wszystkich objawów brucelozy u 20-30% pacjentów objawy choroby mogą powrócić. Wcześniej główną przyczyną śmierci w brucelozie były uszkodzenia serca. Dziś, wraz z pojawieniem się nowych skutecznych leków przeciwbakteryjnych, rokowania na całe życie są pomyślne. Ale poziom zdrowia, zdolność do pracy i jakość życia po chorobie zawsze spadają w mniejszym lub większym stopniu.
Nie ma specyficznej skutecznej szczepionki przeciwko brucelozie dla ludzi. Główne zalecenia dotyczące zapobiegania zakażeniom to:
-
Unikaj spożywania niepasteryzowanych produktów mlecznych;
-
Przestrzeganie zasad higieny i noszenie rękawiczek przez pracowników rolnych;
-
Szczepienia zwierząt domowych. Dzięki masowym szczepieniom bydła problem brucelozy w Stanach Zjednoczonych został prawie całkowicie wyeliminowany.
Ponieważ szczepienie przeprowadza się żywymi, osłabionymi bakteriami, przedostanie się szczepionki do organizmu człowieka może wywołać chorobę.
Po kontakcie ze zwierzęciem zakażonym bakterią brucella, nawet przy braku objawów, konieczna jest uważna obserwacja stanu pacjenta przez 6 miesięcy.